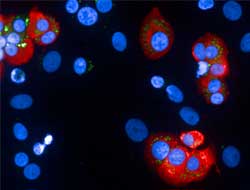

July 26, 2022
A novel study from Monash University in Australia suggests insulin production could be restored in patients with type 1 diabetes, with the help of an existing drug used to treat cancer. The findings of the study…
Source: www.healthcareasia.org – Read more

.webp?w=0&resize=0,0&ssl=1)
